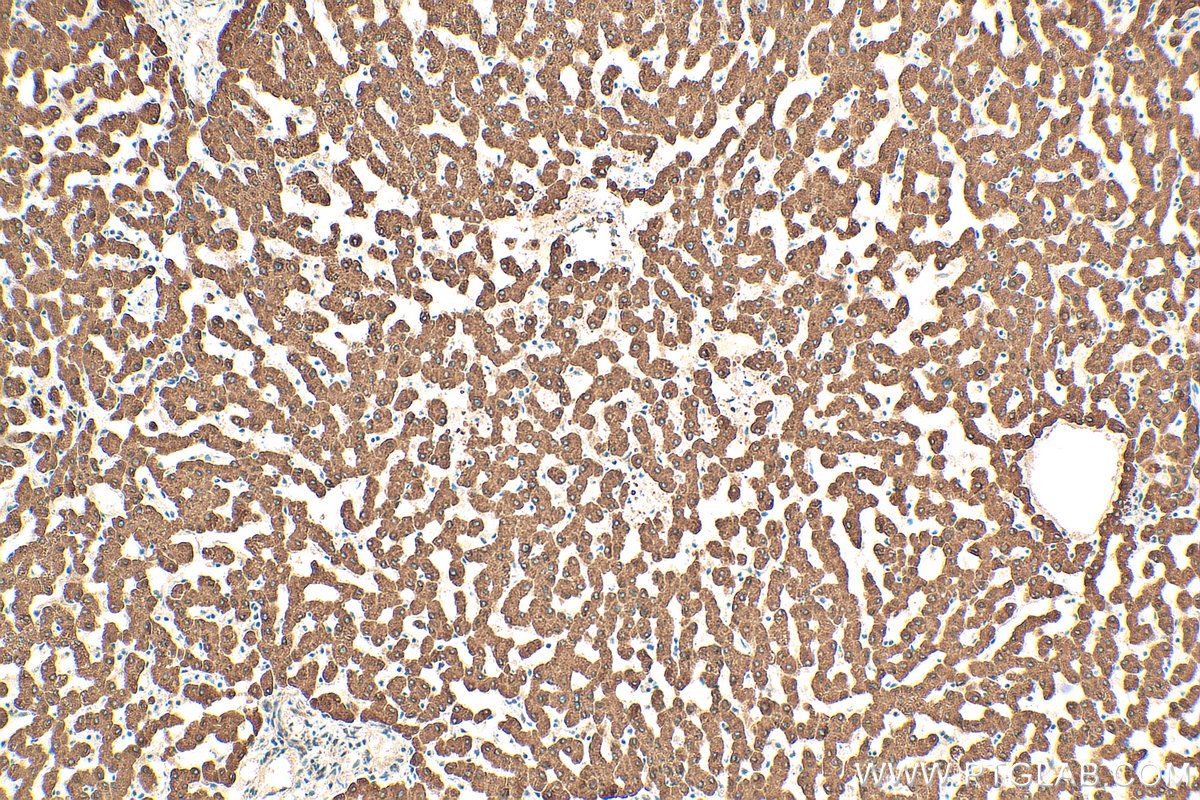
IHC staining of human liver using 10928-1-AP

验证数据展示
经过测试的应用
| Positive WB detected in | L02 cells, Jurkat cells |
| Positive IHC detected in | human liver tissue Note: suggested antigen retrieval with TE buffer pH 9.0; (*) Alternatively, antigen retrieval may be performed with citrate buffer pH 6.0 |
| Positive IF/ICC detected in | HepG2 cells |
推荐稀释比
| 应用 | 推荐稀释比 |
|---|---|
| Western Blot (WB) | WB : 1:200-1:1000 |
| Immunohistochemistry (IHC) | IHC : 1:50-1:500 |
| Immunofluorescence (IF)/ICC | IF/ICC : 1:200-1:800 |
| It is recommended that this reagent should be titrated in each testing system to obtain optimal results. | |
| Sample-dependent, Check data in validation data gallery. | |
产品信息
10928-1-AP targets HSD11B1 in WB, IHC, IF/ICC, ELISA applications and shows reactivity with human samples.
| 经测试应用 | WB, IHC, IF/ICC, ELISA Application Description |
| 文献引用应用 | WB, IHC, IF |
| 经测试反应性 | human |
| 文献引用反应性 | human, mouse, rat |
| 免疫原 |
CatNo: Ag1361 Product name: Recombinant human HSD11B1 protein Source: e coli.-derived, PGEX-4T Tag: GST Domain: 1-292 aa of BC012593 Sequence: MAFMKKYLLPILGLFMAYYYYSANEEFRPEMLQGKKVIVTGASKGIGREMAYHLAKMGAHVVVTARSKETLQKVVSHCLELGAASAHYIAGTMEDMTFAEQFVAQAGKLMGGLDMLILNHITNTSLNLFHDDIHHVRKSMEVNFLSYVVLTVAALPMLKQSNGSIVVVSSLAGKVAYPMVAAYSASKFALDGFFSSIRKEYSVSRVNVSITLCVLGLIDTETAMKAVSGIVHMQAAPKEECALEIIKGGALRQEEVYYDSSLWTTLLIRNPCRKILEFLYSTSYNMDRFINK 种属同源性预测 |
| 宿主/亚型 | Rabbit / IgG |
| 抗体类别 | Polyclonal |
| 产品类型 | Antibody |
| 全称 | hydroxysteroid (11-beta) dehydrogenase 1 |
| 别名 | 11 beta HSD1, 11 DH, 11-beta-HSD1, 11-beta-hydroxysteroid dehydrogenase 1, 11-DH |
| 计算分子量 | 36 kDa |
| 观测分子量 | 65-70 kDa |
| GenBank蛋白编号 | BC012593 |
| 基因名称 | HSD11B1 |
| Gene ID (NCBI) | 3290 |
| RRID | AB_2119527 |
| 偶联类型 | Unconjugated |
| 形式 | Liquid |
| 纯化方式 | Antigen affinity purification |
| UNIPROT ID | P28845 |
| 储存缓冲液 | PBS with 0.02% sodium azide and 50% glycerol, pH 7.3. |
| 储存条件 | Store at -20°C. Stable for one year after shipment. Aliquoting is unnecessary for -20oC storage. |
背景介绍
HSD11B1(Corticosteroid 11-beta-dehydrogenase isozyme 1) is also named as HSD11, HSD11L,11-DH and 11-beta-HSD1.It is a microsomal enzyme, which acts mainly as a NADP(H)- dependent reductase converting inactive cortisone (E) to active cortisol (F), thus regulating intracellular F access to glucocorticoid receptor. This enzyme is widely expressed not only in liver and adipose tissue, but also in adrenal, ovary and decidua.Western blot analysis in human liver, using a specific11-beta-HSD1 antibody, showed two bands at approximately 34 and 68 kDa confirming the dimeric nature of 11-beta-HSD1 in liver. In omental adipose tissue, an additional band of 50 kDa was strongly expressed(PMID:16914598).
实验方案
| Product Specific Protocols | |
|---|---|
| IF protocol for HSD11B1 antibody 10928-1-AP | Download protocol |
| IHC protocol for HSD11B1 antibody 10928-1-AP | Download protocol |
| WB protocol for HSD11B1 antibody 10928-1-AP | Download protocol |
| Standard Protocols | |
|---|---|
| Click here to view our Standard Protocols |
发表文章
| Species | Application | Title |
|---|---|---|
Brain Behav Immun HMGB1-mediated differential response on hippocampal neurotransmitter disorder and neuroinflammation in adolescent male and female mice following cold exposure. | ||
J Assist Reprod Genet Effect of luteinizing hormone concentration on transcriptome and subcellular organelle phenotype of ovarian granulosa cells. | ||
Int J Biol Sci 11β-Hydroxysteroid Dehydrogenase Type 1 Facilitates Osteoporosis by Turning on Osteoclastogenesis through Hippo Signaling | ||
Gynecol Endocrinol N6-methyladenosine demethylase FTO related to hyperandrogenism in PCOS via AKT pathway | ||
Geroscience Adipose chemokine ligand CX3CL1 contributes to maintaining the hippocampal BDNF level, and the effect is attenuated in advanced age
| ||
Prog Neuropsychopharmacol Biol Psychiatry Sex-specific metabolic and inflammatory alterations in adult animals vulnerable to prenatal stress exposure |